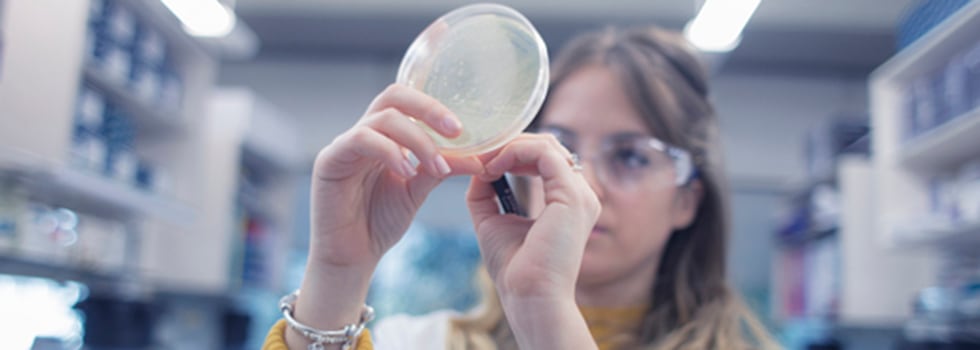

The rising number of people who are overweight or obese in countries around the world has created a growing need for effective, scientifically-validated weight management interventions. The probiotic industry can address this need but has been slow to develop condition-specific strains and show they drive improvements in meaningful endpoints. To fill this gap, ADM Biopolis used its novel approach and screening platform to develop a validated weight management strain: Bifidobacterium lactis BPL1.
BPL1 enters a market in dire need to better ways to manage weight and reduce fat. Since 1975, the worldwide prevalence of obesity has nearly tripled, resulting in more than 650m adults having a body mass index (BMI) of 30 or more as of 2016.1 Almost 40% of adults — 1.9bn people — are overweight.
Data on the numbers of overweight children provide reasons to think these figures may continue to rise. Around 340m children aged five to 19 years old are overweight. An estimated 41m children aged five and under are overweight.
The numbers suggest many countries around the world are heading toward a health crisis, the so called globesity. Weight is a major risk factor for many of the conditions that are the biggest killers and burdens on healthcare systems, including diabetes, cardiovascular diseases and cancer. Unchecked, the rising prevalence of people with BMIs above 25 could drive increases in these diseases and other chronic conditions.
This situation has emerged despite public health bodies, businesses and individuals committing time and money to weight management efforts. The failure of these efforts has left people distrustful of many fat reduction initiatives, as shown by declining interest in dieting and fat-free foods, skepticism about weight management products and the low uptake of dietary supplements for weight loss.2-4
New, scientifically-validated approaches are needed to rebuild trust in weight management interventions and help people live lifestyles that enable them to reach and maintain healthy weights.
How ADM Biopolis discovered BPL1
ADM Biopolis detected the market need for better weight management probiotics and responded by applying its novel philosophy and R&D strategy to the task. The novel approach, which has helped ADM Biopolis grow into a leader in microbial biotechnology, places a far greater emphasis than is typical on screening. Many probiotic companies only use screening to look at the phenotype and biochemical features of a strain, if they perform it at all, and shy away from developing condition-specific products.
At ADM Biopolis, the discovery and development process begins with the identification of a health target that needs tackling. ADM Biopolis then screens strains isolated from healthy humans to identify the probiotic strain or combination of strains that best fits its targeted profile.
In the case of BPL1, ADM Biopolis set out to identify a strain with favorable weight management properties by using the nematode C. elegans as an in vivo fat reduction model. The screen identified Bifidobacterium lactis BPL1, a strain isolated from the feces of a breastfed baby, as the most promising bacteria of the more than 35 tested by ADM Biopolis.
Few companies are equipped to undertake such a rigorous, systematic search for a condition-specific strain, largely because the costs can be prohibitive in the absence of specialist technology. ADM Biopolis’ screening platform reduces the cost of the process and decreases the risk of expensive setbacks later in development by providing a solid scientific grounding for further investment.
Experience has taught ADM Biopolis that strains that perform well in its screens are likely to be effective in animal models and clinical trials, giving it the confidence to embark on full development programs on the strength of early-stage results.
In the case of BPL1, ADM Biopolis bolstered the screening data by running transcriptomic and metabolomic tests to elucidate the strain’s mechanisms of action. The experiments showed BPL1 acts on metabolic pathways found in both the nematode and humans, increasing ADM Biopolis’ confidence that the results would translate into the clinic, and revealed that the strain has potent antioxidant properties.
Showing BPL1 works when heat killed
ADM Biopolis confirmed the potential of BPL1 in two placebo-controlled studies in animal models of obesity before initiating a human clinical trial. The trial enrolled 135 abdominally overweight subjects and randomized them to receive daily doses of either placebo, alive BPL1 or heat-killed BPL1.
After three months, subjects who received either form of BPL1 experienced significant reductions in waist circumference and abdominal visceral fat compared to placebo. Waist reductions of 1.75cm and 1.9cm were seen in the alive and heat-killed BPL1 cohorts, respectively. Subjects in the placebo arm experienced reductions of 0.2cm.
The broad pattern seen in the waist reduction data was replicated against other endpoints, such as changes in BMI and an index of abdominal obesity. In each case, both versions of BPL1 outperformed placebo, with the heat-killed version often performing as well or even better than the alive version.
That is an important finding. Many probiotic strains need to be alive to have the desired effect, which limits the breadth of applications in which they can be used. Applications in the beverage, bakery and confectionery categories — among others — are closed off to live strains for technological reasons, such as the fact that aspects of the production process kill the bacteria.
Some strains overcome these limitations as their effects are caused by cellular components that act on the human body even if the bacteria is dead. The clinical trial data and earlier-stage evidence show BPL1 is such a strain, positioning ADM Biopolis to provide the probiotic in a heat-killed or live, inactivated form depending on the needs of its customers.
That prospect has caught the attention of the industry, leading to the nomination of BPL1 as a finalist in the weight management ingredient of the year category in the 2019 NutraIngredients Awards.
The future of weight management
ADM Biopolis’ development program up to and including the clinical trial showed BPL1 is a strain with a unique, valuable set of characteristics. The clinically-demonstrated ability of the probiotic to drive significant reductions in key weight management variables when heat killed opens the door to new ways to help people control their weight, from yogurts and beverages to rice cakes and ice creams.
ADM Biopolis is building on this platform of evidence in support of the use of BPL1 by running further clinical trials and assessing the effects of the strain when used in combination with other ingredients in its broad product portfolio.
The research has uncovered synergistic combinations that increase the effects of BPL1. In one test, ADM Biopolis assessed the effect of combining functional soluble fiber Fibersol and BPL1 in a beverage. The combination induced a 35% reduction in fat, as compared to declines of 18.7% and 12.7% in the BPL1 and Fibersol experiments, respectively. The results come from preclinical models but ADM’s experience with BPL1 suggests they are likely to translate into humans.
ADM Biopolis also has the capacity to combine BPL1 with prebiotics, plant-based proteins, flavors, acidulants, emulsifiers, vitamins, DHA and plant sterols from its large ingredient portfolio, enabling it to support the creation of custom products that meet the specific needs of clients and end users. The flexibility this provides is illustrated by the use of BPL1 in skin health products for its antioxidant properties.
Equipped with this flexible platform and data validating the effects of BPL1, ADM Biopolis is positioned to help manufacturers deliver weight management probiotics designed to support healthy lifestyles.
References
1. Obesity and overweight. World Health Organization Available at: http://www.who.int/news-room/fact-sheets/detail/obesity-and-overweight. (Accessed: 16th April 2019)
2. New Research Proves Millennials Are Upsetting the Grocery Cart with Their Focus on Fresh, Fitness and Flavor. Available at: https://www.prnewswire.comnew-research-proves-millennials-are-upsetting-the-grocery-cart-with-their-focus-on-fresh-fitness-and-flavor-300526046. (Accessed: 16th April 2019)
3. NHANES 2013-2014: Dietary Supplement Use 30-Day - Individual Dietary Supplements Data Documentation, Codebook, and Frequencies. Available at: https://wwwn.cdc.gov/Nchs/Nhanes/2013-2014/DSQIDS_H.htm#DSQ128N. (Accessed: 16th April 2019)
4. Valentine, A. A., Schumacher, J. R., Murphy, J. & Ma, Y. J. Dietary supplement use, perceptions, and associated lifestyle behaviors in undergraduate college students, student-athletes, and ROTC cadets. J Am. Coll. Health 66, 87–97 (2018).